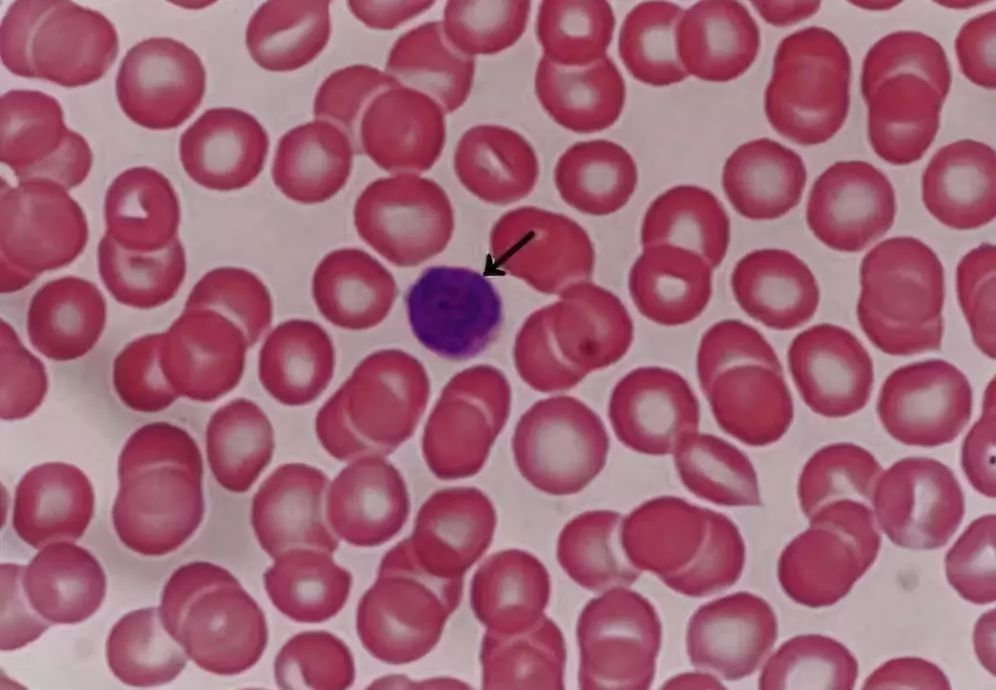
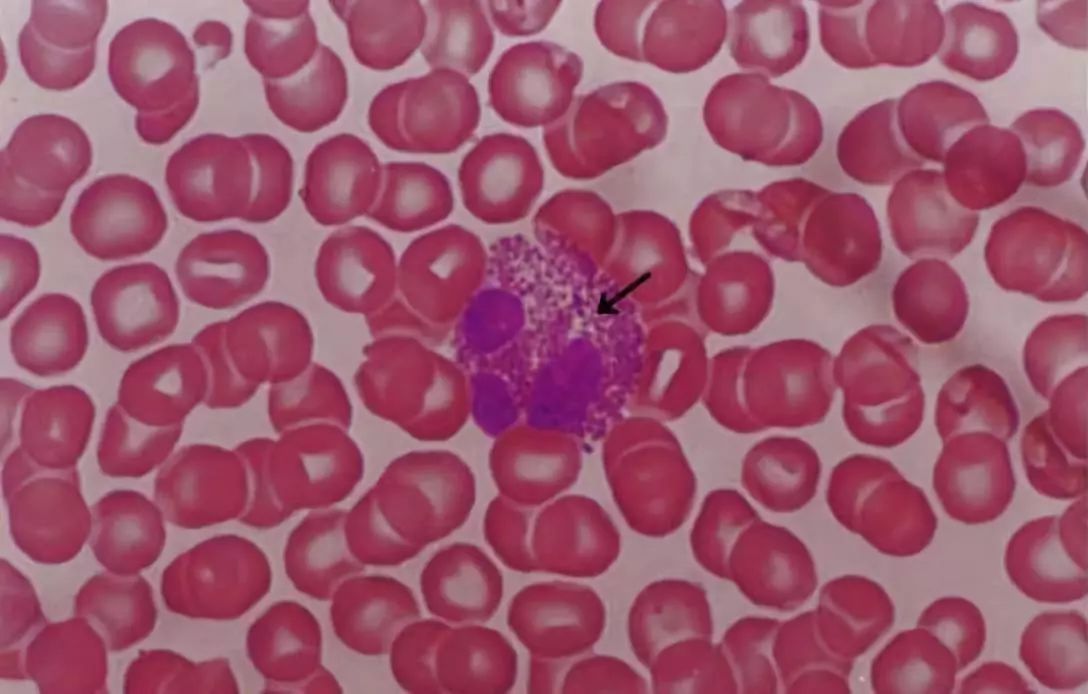

【光镜观察技巧】
主要针对白细胞。
1.白细胞的大小可以参照红细胞的直径进行确定,红细胞直径约为7.5μm,白细胞的直径通 常在2-3个红细胞直径大小。
2.细胞核的分叶:中性粒细胞的细胞核分叶较多,一般在3个叶及以上。单核细胞从名字上看,就是核不分叶的意思。
3.仔细观察细胞质中是否存在较多的颗粒,如果颗粒较多,较明显,是有粒白细胞。反之,为无粒白细胞。
4.仔细观察胞质中颗粒的染色特性。红色的颗粒为嗜酸性颗粒(嗜酸性粒细胞),蓝色的颗粒为嗜碱性颗粒(嗜碱性粒细胞),淡紫色或淡红色的为中性颗粒(中性粒细胞)。
5.小淋巴细胞与红细胞大小相似,浓染的细胞核基本占据了大部分细胞体积,细胞质少,染成天蓝色。
【图片观察和学习】

图1. 血涂片光镜像(Wright 染色)
箭头指示的是中性粒细胞。为球形细胞,直径10-12μm,分叶核,胞质粉红色,内含细小的,分布均匀的淡紫色和淡红色颗粒。
图2. 血涂片光镜像(Wright 染色)
箭头指示的是淋巴细胞(小淋巴细胞),球形细胞,直径6-8μm,与红细胞直径相仿。核圆形,染色深,一侧常有小凹陷,胞质很少,染成天蓝色。

图3.血涂片光镜像(Wright 染色)
箭头指示的是单核细胞,球形细胞,直径14-20μm,核肾形、马蹄形或卵圆形,染色较浅,胞质丰富,染成灰蓝色。
图4. 血涂片光镜像(Wright 染色)
箭头指示的是嗜酸性粒细胞,球形细胞,直径10-15μm,分叶核,多为两叶,胞质内充满粗大的、分布均匀的、红色颗粒。

图5. 血涂片光镜像(Wright 染色)
箭头指示的是嗜碱性粒细胞,球形细胞,直径10-12μm,分叶核,胞质内含有大小不一、分布不均、蓝紫色的颗粒。

图6. 血涂片光镜像(Wright 染色)
箭头指示的是血小板,双凸扁盘形,直径2-4μm,中央有颗粒,为颗粒区,周边弱嗜碱性,为透明区。

图7. 血涂片光镜像(Wright 染色)
箭头指示的是红细胞,双凹圆盘形,直径7-8μm,中央薄,染色淡,周边厚,染色较深,无核无细胞器。

图8. 结缔组织中的白细胞(HE染色)
白细胞要离开血管到组织中发挥作用。图中1示红细胞胞,存在于血管中。2示中性粒细胞(尚未离开血管),可见明显的分叶核,胞质细小粉红色颗粒。3示结缔组织中的嗜酸性粒细胞,细胞核分叶不明显,胞质内见大量均匀的红色颗粒。4示结缔组织中的淋巴细胞,细胞小,核异染色质丰富,染色深。此处结缔组织中有如此多的嗜酸性粒细胞等白细胞,通常是病理表现。

图9. 血液涂片示网织红细胞(煌焦油蓝染色)
从骨髓进入血液尚未完全成熟的红细胞称为网织红细胞(reticulocyte),蓝色箭头指示。可见网织红细胞比成熟红细胞(红色箭头)大,胞质内含有蓝色的细网或颗粒,是残留的核糖体,仍然具有合成血红蛋白的功能。一般在进入血液1-3天后,网织红细胞中的核糖体等细胞器消失,成为成熟红细胞。网织红细胞计数是判断骨髓生成红细胞能力的指标之一,对于血液病的诊断、疗效的观察和预后的评估有重要意义。

